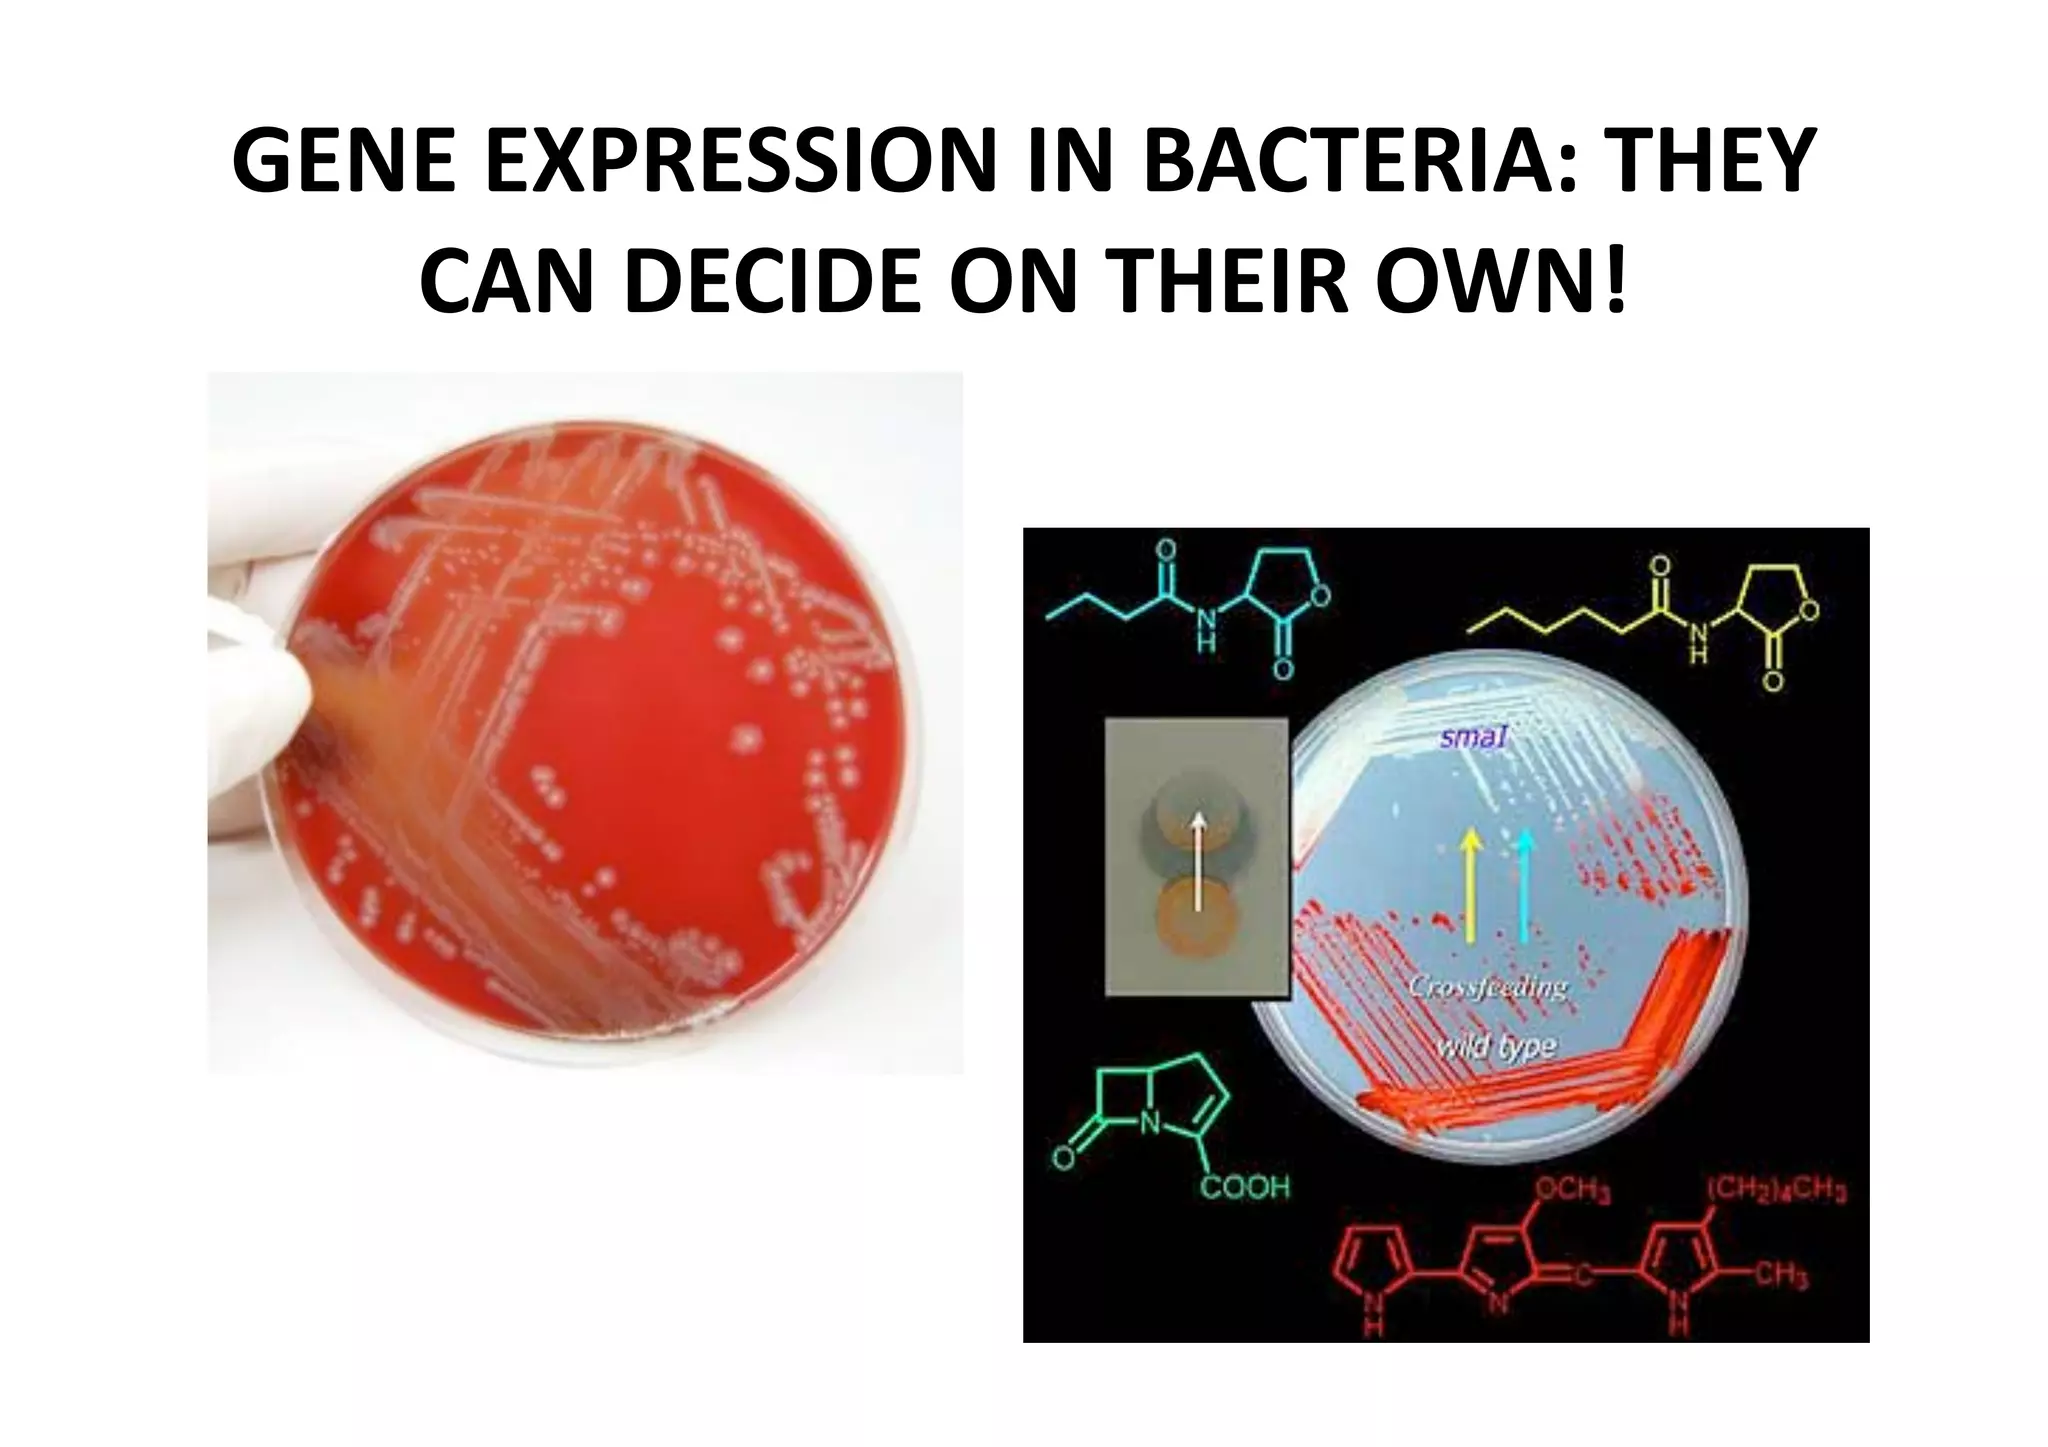
GENE EXPRESSION IN BACTERIA: THEY 
   CAN DECIDE ON THEIR OWN!

The document outlines the key requirements and important dates for the NS2 Biology portion, including two examinations, a group project, and other assignments. Students are divided into plant and animal project groups. The lectures will cover the introduction to homeostasis for the first examination. Key theories on the origin of life are also summarized, such as the biochemical theory, theory of spontaneous generation, interplanetary theory, and theory of special creation. Finally, the characteristics of life are defined as organization, metabolism, reproduction, growth and development, response to stimuli, and adaptation.